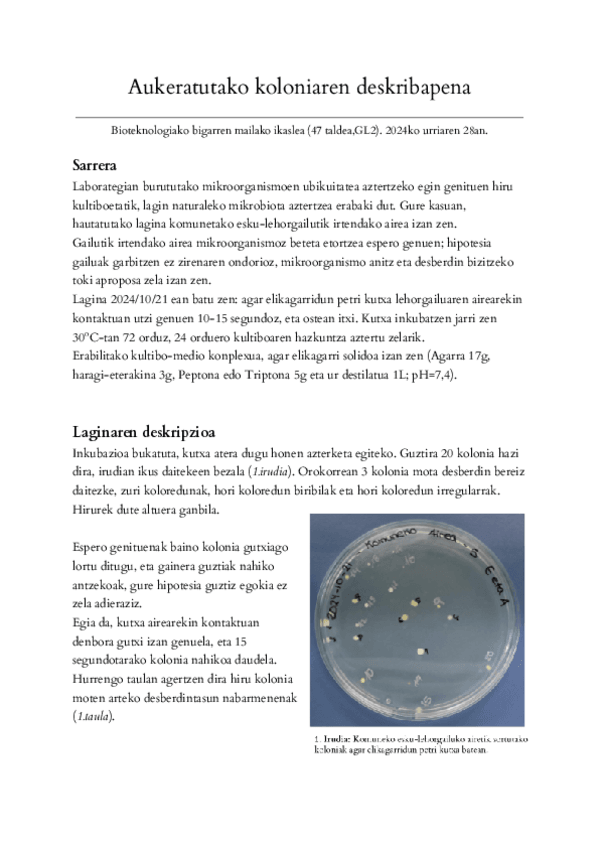

@User_3333
85 Publicaciones
719 Interacciones
4 Seguidores
12 Siguiendo
Lista de publicaciones de User_3333
He publicado nuevos practicas de 3º Metabolismo y Fisiología Vegetal: LABORATEGIKO-GALDERAK.pdf
ejercicios
-
2 partzialeko ariketak eskuz
He publicado nuevos ejercicios de 3º Transferencia de Materia: 2 partzialeko ariketak eskuz
He publicado nuevos ejercicios de 3º Diseño de Reactores: 1-partzial-ariketak.pdf
He publicado nuevos ejercicios de 3º Diseño de Reactores: 2-Partzial-Ariketak.pdf
He publicado nuevos apuntes de 3º Transferencia de Materia: 1-eta-2-Teoria--1234-galdetegiak.pdf
He publicado nuevos ejercicios de 3º Fisiología Animal: Oinarrizko-kontzeptuakGA-galderak.pdf
He publicado nuevos examenes de 3º Fisiología Animal: Azterketak-erantzunda.pdf
He publicado nuevos practicas de 2º Cultivos Celulares y Tisulares: Histo-praktiketako-argazkiak--azalpen-laburrak.pdf
He publicado nuevos test de 2º Inmunología: Test-motako-galderak-2025.pdf
He publicado nuevos apuntes de 2º Microorganismos y Producción Industrial: 8.-gaia-arkeo-eta-Gram-laburpena.pdf
He publicado nuevos apuntes de 2º Microorganismos y Producción Industrial: 6.-gaia-laburpena.pdf
apuntes
-
Teknika Instrumentalak Teoria osoa + Journal Club
He publicado nuevos apuntes de 2º Técnicas Instrumentales: Teknika Instrumentalak Teoria osoa + Journal Club
He publicado nuevos practicas de 2º Termodinámica y Cinética Química: konplexuak-praktikako-galderak.pdf
He publicado nuevos practicas de 2º Termodinámica y Cinética Química: 1.-Neutralizazio-eta-disoluzio-entalpia.pdf
He publicado nuevos practicas de 2º Microbiología: Aukeratutako-koloniaren-txostena.pdf
He publicado nuevos practicas de 2º Microbiología: Laborategi-azterketarako-galderak.pdf